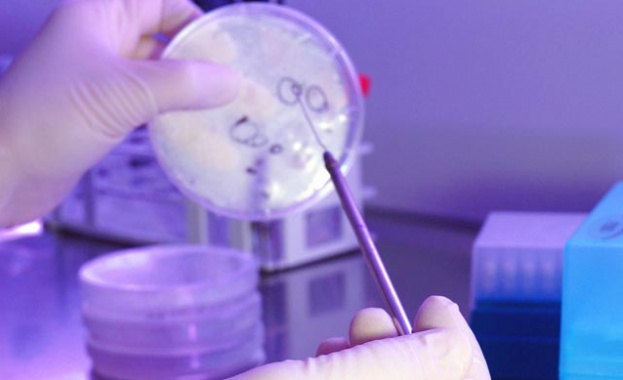
Над 420 млн. лв. са предвидени за наука през 2017 г.

-
 04 Юли 2026 |
04 Юли 2026 |
 USD / BGN 1.1448
USD / BGN 1.1448 GBP / BGN 0.8572
GBP / BGN 0.8572 CHF / BGN 0.9190
CHF / BGN 0.9190- Радиация: София 0.11 (µSv/h)
- Времето:
 София 0°C
София 0°C 
Над 420 млн. лв. са предвидени за наука през 2017 г.
31 Октомври 2016 | 17:25
/КРОСС/ Над 420 млн. лв. ще отидат за наука през следващата година, заяви зам.-министърът на образованието и науката проф. Иван Димов, който се срещна с ръководството на БАН, Селскостопанската академия, синдикатите в науката и Националното представителство на студентските съвети. Бюджетът на БАН е увеличен с 6.8% за 2017 г. от 73 на 78 млн. лв., подчерта проф. Димов. Това е по-голямо увеличение отколкото за висшите училища, където средствата нарастват с 2.8%. Данните показват, че науката е приоритет за МОН и за правителството и увеличението е на фона на бюджетните ограничения в страната, каза проф. Иван Димов.
В науката ще влязат още 350 млн. лв. през следващата година по Оперативна програма "Наука и образование за интелигентен растеж". По-голямата част от тези средства ще влязат именно в БАН. Младите учени са стимулирани по проект, за който са отделени 2 млн. лв.
Заедно сме от едната страна на барикадата. МОН предприема стъпки за увеличаване на средствата за наука във всички направления, допълни още зам.-министър Димов.